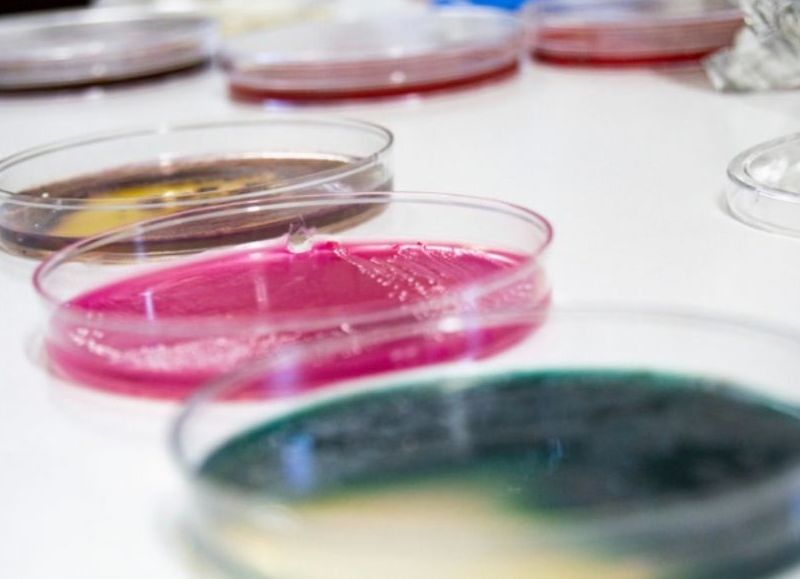

Se realizó un estudio sobre los microorganismos contaminantes en la calidad de las cervezas artesanales
Investigadores/as y becarios/as de los institutos IPATEC y PROBIEN (CONICET – UNComahue) realizaron por primera vez un estudio en Argentina que evidencia la importancia de la incidencia de los microorganismos contaminantes en la calidad de las cervezas artesanales.
La cerveza se elabora principalmente con agua, malta de cebada, lúpulo y levaduras cerveceras específicas encargadas de la fermentación alcohólica.
Investigadores/as y becarios/as de los institutos IPATEC y PROBIEN (CONICET – UNComahue) realizaron un estudio en Argentina que evidencia la importancia de la incidencia de los microorganismos contaminantes en la calidad de las cervezas artesanales. https://t.co/JAc1Crf2Ha pic.twitter.com/tWLvooRnGL
— Prensa UNComa (@prensaunco) July 10, 2022
La presencia de otros microorganismos, como bacterias o levaduras no cerveceras (denominadas salvajes), puede comprometer notoriamente las características sensoriales del producto como el aumento de acidez, aromas y sabores no deseados) lo que genera una reducción de su calidad y vida útil.
Es de destacar que estos contaminantes por lo general no son dañinos para la salud, siempre y cuando las cervezas cumplan con las especificaciones del Código Alimentario Argentino respecto del pH y contenido mínimo de alcohol.
Este trabajo de investigación, llevado a cabo por los/las investigadores/as del IPATEC (CONICET-UNComahue) Mailen Latorre, Clara Bruzone, Diego Libkind y Virginia De García del PROBIEN (CONICET-UNComahue), fue realizado en el año 2015 en 75 cervezas artesanales embotelladas provenientes de 37 cervecerías de 12 localidades andinas distribuidas desde el norte de Neuquén a Tierra del Fuego. Además, fue publicado en español en la Revista Argentina de Microbiología y es la primera vez que se realiza en nuestro país.
La incidencia de microorganismos contaminantes es la principal causa que afecta la calidad en la cerveza a nivel mundial, y este estudio evidencia que Patagonia Andina y Argentina en general no escapan a esta problemática. Es por ello que desde el IPATEC se brinda apoyo técnico en esta temática y se promueven acciones para encontrar soluciones integrales que eleven la calidad y eviten la pérdida de productos.
A las muestras se les realizaron estudios físico-químicos, microbiológicos y sensoriales, y a los microorganismos aislados se los identificó genéticamente. Los resultados indicaron que, de cada 10 fábricas estudiadas, 8 presentaron algún tipo de problemas de contaminación con microorganismos, lo que pone en evidencia la necesidad de diseñar estrategias de prevención y control de contaminaciones en microcervecerías.
La bacteria Levilactobacillus brevis y la levadura Saccharomyces cerevisiae (variantes no cerveceras) fueron los principales contaminantes identificados.
En el marco de la promoción de acciones destinadas a mejorar la calidad de las cervezas artesanales, el Centro de Referencia de Levaduras y Tecnología Cervecera (CRELTEC) del IPATEC viene trabajando en forma conjunta y colaborativa con la Asociación de Cerveceros Artesanales de Bariloche y Zona Andina en esta temática hace tiempo, fruto de este intercambio se obtuvo financiación del Ministerio de Producción de la Nación, lo cualpermitió que 11 productores recibieran equipamiento y entrenamiento para controles de calidad en fábrica. Además, se vienen realizando numerosas capacitaciones a productores sobre la temática en las 5 provincias patagónicas y en el resto del país en el marco del programa Ciencia y Cerveza (https://www.conicet.gov.ar/cienciaycerveza/).
Este trabajo representa una parte de la tesis doctoral de la Lic. Mailen Latorre (IPATEC) y fue publicado recientemente en la Revista Argentina de Microbiología, en idioma castellano y con acceso gratuito para que los productores artesanales de la Argentina tengan acceso a la información (ver link abajo).
La incidencia de microorganismos contaminantes es la principal causa que afecta la calidad en la cerveza a nivel mundial, y este trabajo demuestra que la Patagonia Andina y la Argentina en general, no escapan a esta problemática. Este primer estudio brinda la confirmación científica de esta realidad del sector. Las acciones de apoyo técnico del IPATEC se promueven acciones para encontrar soluciones integrales que eleven la calidad y eviten la pérdida de productos.
Link a la publicación: https://www.sciencedirect.com/science/article/pii/S0325754122000323?via%3Dihub